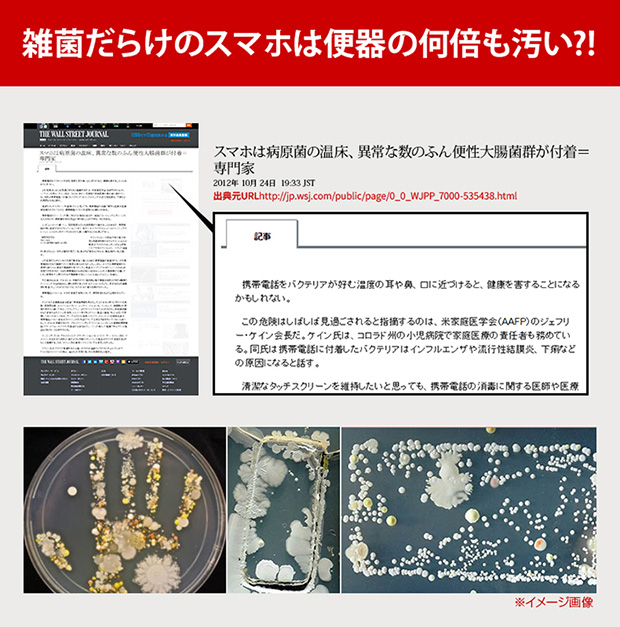
雑菌だらけのスマホは便器の何倍も汚い?!

アイサポの修理はiPhoneの外観、iPhoneの内部、そして目に見えない雑菌までもキレイにします!
みなさんが毎日使うiPhoneは実は雑菌だらけ!
菌はどこにでも生息するものですが、iPhoneの表面温度がバクテリアにとって繁殖にちょうどいい温度になっているため、菌が増殖してしまいます。
過去にはこんな記事も!
iPhone修理のついでに、5分でキレイに除菌します!

除菌効果の高いUV-C領域の紫外線を照射して、お預かりしたiPhoneの表面を強力に直接除菌します。
「Dr.カプセル」のUVランプから4種の菌液で99.9%の菌が除菌されています。(第三者機関「K.C. Laboratories」での実証試験済み)
※全ての菌に有効ではありません。

わずか5分間、お預かりしたスマートフォンに被せてスイッチを押すだけで99.9%除菌完了!
修理のついでに無料で実施中です!!


